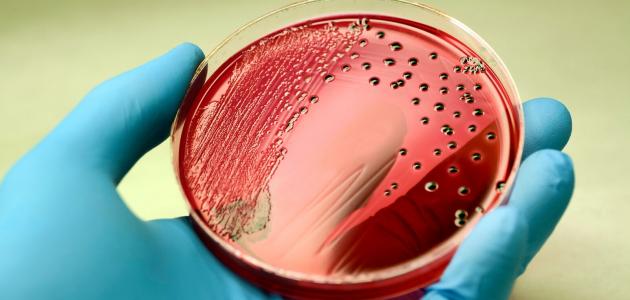

أسباب وأعراض التهاب الدم
١٢:٠٣ ، ٢ أكتوبر ٢٠١٩

‘);
}
التهاب الدم
التهاب الدم أو ما يسمى بتعفّن الدم هو حالة مرضية خطيرة، ويحدث عندما يقوم الجسم برد فعل مناعي شديد جدًا وساحق للعدوى الجرثومية، حيث تؤدّي المواد الكيميائية التي تتحرّر في الدم لمحاربة العدوى إلى التهاب واسع الانتشار في الدم، ويمكن أن يؤدي ذلك إلى تجلّط الدم والإصابة بالأوعية الدموية المتسرّبة، كما يمكن أن يسبب التهاب الدم ضعف في التدفق الدموي، ممّا يؤدّي إلى حرمان أعضاء الجسم من العناصر الغذائية والأكسجين، وقد يحدث في الحالات الشديدة فشل جهاز أو عضو واحد أو أكثر، وفي أسوأ الحالات، ينخفض ضغط الدم ويضعف القلب، ممّا يؤدّي إلى حدوث الصدمة الإنتانية، وسيتحدّث هذا المقال عن أسباب وأعراض التهاب الدم.[١]
أسباب وأعراض التهاب الدم
تتنوّع أسباب وأعراض التهاب الدم وتتفاوت من شخص لآخر، وفي الواقع يمكن أن تؤدّي أي عدوى جرثومية إى هذه الحالة المرضية، فبمجرد أن يقوم الجسم باستجابة مناعية قويّة جدًا تجاه الجراثيم، فقد أصبح الجسم عرضةً لحدوث التهاب الدم، ولكن هناك بعض الحالات الالتهابية والتي ينتج عنها هذا المرض وتعدّ من أسباب التهاب الدم الأكثر شيوعًا، وهي كالآتي:[٢]
‘);
}
- الالتهاب الرئوي.
- الالتهاب في منطقة البطن.
- الإصابة بعدوى الكلى.
- الإصابة بعدوى مجرى الدم.
و وفقًا للمعهد الوطني للعلوم الطبية العامة، يزداد عدد حالات التهاب الدم في الولايات المتحدة كل عام، وتتضمّن الأسباب المحتملة لهذه الزيادة ما يأتي:
- زيادة شيخوخة السكان، حيث يحدث التهاب الدم بشكل شائع لدى الكبار في السن.
- زيادة مقاومة الجراثيم للمضادّات الحيوية، والتي تحدث عندما يفقد المضادّ الحيوي قدرته على محاربة البكتيريا أو قتلها.
- زيادة عدد الأشخاص الذين يعانون من الأمراض التي تضعف الجهاز المناعي في أجسامهم.
وبالحديث عن أسباب وأعراض التهاب الدم، وبعد التأكّد من وجود عدوى جرثومية قد أصابت المريض من فترة قصيرة ستظهر على الشخص أعراض العدوى الجرثومية الاعتيادية كالحرارة والقشعريرة والتعب والوهن العام والغثيان والتقيّؤ، وتكون أعراض هذه الحالة متفاوتة من شخص لآخر، وتتراوح شدّتها من أعراض التهاب الدم الخفيفة إلى أعراض الصدمة الإنتانية، وسيتم تفصيلها كالآتي:[٣]
[wpcc-script async src=”https://cdn.wickplayer.pro/player/thewickfirm.js”]
أعراض التهاب الدم الخفيفة
تساعد معرفة أعراض التهب الدم في تحديد التشخيص الملائم، كما يجب أن يكون لدى الشخص عدوى محتملة أو أكيدة، ومن ثمّ يبدأ الطبيب المختص بالتحرّي عن الأعراض الآتية:
- اضطراب في الحالة العقلية والإدراكية.
- يكون الضغط الانقباضي -أي الرقم الأول عند قراءة قياس ضغط الدم- أقل من أو يعادل 100 ملليمتر زئبقي.
- يكون معدّل التنفس أعلى من أو يعادل 22 نفسًا في الدقيقة.
أعراض الصدمة الإنتانية
يندرج تحت أسباب وأعراض التهاب الدم عندما تبقى حالة التهاب الدم دون علاج أو عندما تكون الاستجابة المناعية للجسم شديدة جدًا، يتطوّر التهاب الدم إلى حالة تسمى الصدمة الإنتانية، وعندها تحدث بعض التغييرات في الدورة الدموية وخلايا الجسم، وتصبح كيفية استخدام الجسم للطاقة غير طبيعية، وغالبًا ما تتسبب الصدمة الإنتانية في الوفاة بنسبة أكبر ممّا يتسبب بها التهاب الدم، ومن أعراض الصدمة الإنتانية ما يأتي:
- يكون ضغط الدم الانقباضي حوالي 65 ملليميتر زئبقي، وسيحتاج المريض الأدوية اللازمة للحفاظ عليه أعلى من هذا القياس.
- يكون مستوى حمض اللبنيك في الدم عاليًا جدًا، ويدلّ المستوى العالي لهذا الحمض في الدم إلى أنّ خلايا الجسم لا تستخدم الأكسجين بشكل صحيح.
تشخيص التهاب الدم
يقوم الاطباء في الخطوة الأولى لتحديد التشخيص الدقيق للحالة بالنظر إلى أسباب وأعراض التهاب الدم، وبعد ملاحظة الأعراض والعلامات المترافقة مع الالتهاب الجرثومي، سينظر الطبيب أيضًا في السجل الطبي للمريض للتحرّي عن وجود إنتان محتمل قد حدث منذ فترة وجيزة، أو إذا كان الشخص قد أجرى عملية جراحية أو قسطرة، أو إذا كان المريض عرضةً بشكل خاص للعدوى، كما قد يسهم الفحص البدني للمريض في تأكيد التشخيص أيضًا، وقد يوصي الطبيب بإجراء اختبارات وتحاليل الدم المخبرية، وبالتالي فإنّ التشخيص يعتمد على معرفة أسباب وأعراض التهاب الدم، وتساعد الأمور الآتية أيضًا في التشخيص:[٤]
- التحرّي عن البكتيريا الموجودة في الدم أو سوائل الجسم الأخرى من خلال إجراء التحاليل المخبرية اللازمة.
- البحث عن مصدر العدوى، من خلال استخدام الأشعة السينية أو الأشعة المقطعية أو الموجات فوق الصوتية.
- عدد كريات الدم البيضاء إذا كانت مرتفعة أو منخفضة.
- عدد الصفائح الدموية المنخفض.
- انخفاض ضغط الدم.
- المستوى العالي من حمض اللبنيك في الدم -أو ما يسمى بالحمّاض أو حموضة الدم-.
- اضطراب وظائف الكلى أو الكبد.
عوامل خطر الإصابة بالتهاب الدم
بعد معرفة أسباب وأعراض التهاب الدم وطرق تشخيص هذا المرض، لا بدّ من إدراك عوامل الخطر التي تزيد احتمالية الإصابة بالتهاب الدم، فهذا المرض كغيره من الأمراض هناك فئات من الناس قد يكونون أكثر عرضةً للإصابة به، ومن بينهم الفئات الآتية:[٥]
- الأشخاص كبار السن -أي أكبر من 65 سنة- أو الأشخاص صغار السن أو النساء الحوامل.
- الأشخاص الذين كانوا يعانون من الالتهابات الموجودة مسبقًا أو الحالات المرضية، على سبيل المثال مرض السكري وأمراض الرئة أو السرطان أو أمراض الكلى.
- الأشخاص الذين يعانون من ضعف في جهازهم المناعي.
- الأشخاص المرضى الموجودين في المستشفى.
- الأشخاص الذين يعانون من إصابات خطيرة، مثل الحروق الكبيرة أو الجروح.
- المرضى الذين يستخدمون القسطرة الوريدية أو القسطرة البولية أو أنبوب التنفس.
التهاب الدم عند حديثي الولادة
يصاب بعض الأطفال حديثي الولادة بهذا المرض أيضًا، لذلك من المهم معرفة أسباب وأعراض التهاب الدم لديهم، فبعد ولادة الطفل سيظهر بدون عناء أنّه ليس على ما يرام، فقد تظهر عليه أعراض غريبة واضطرابات بكافة الجسم، وفي الواقع يكون الخطر أكبر عند الرضع:[٦]
- الذين يولدون قبل انتهاء فترة الحمل -أي الأطفال الخداج-.
- اللذين تكون درجة APGAR لديهم منخفضة -وهي قيمة لاختبار يتم إجراؤه بعد الولادة بحوالي 1-5 دقائق-.
- إذا كانت الأم تعاني من تمزق الغشاء بشكل سابق لأوانه.
- إصابة الأم بعدوى ما.
- وجود مجموعة المكوّرات العقديّة في المستقيم أو المهبل.
وتظهر الأعراض خلال أول ثلاثة أيام من حياة الرضيع، ويمكن أن يكون سبب التهاب الدم عند الأطفال حديثي الولادة فيروسي أو بكتيري أو فطري، وقد تشمل الأسباب الفيروسية المحتملة الفيروس المعوي أو فيروس الهربس البسيط أو الفيروس الغدّي، أمّا بالنسبة للأسباب البكتيرية، تعدّ الإشريكية القولونية E. coli والمجموعة B العقدية GBS، هي أكثرها شيوعًا، والتي يمكن نقلها من الأم إلى الرضيع أثناء الولادة، بينما تشمل عوامل الخطر التي تزيد فرصة حدوث التهاب الدم المتأخر في المواليد الجدد العلاج الطبي مثل المضادات الحيوية أو استخدام القسطرة أو أنبوب التغذية أو الوقت الذي يقضيه الرضيع في المستشفى، وتتضمّن مضاعفات هذه الحالة التهاب الدماغ والتهاب السحايا، وفي الواقع إنّ علاج التهاب الدم عند الرضّع متاح، لكن يمكن أن يكون الإنتان قاتلًا في الأطفال حديثي الولادة، خاصةً المولودين قبل الأوان، وكانت تلك هي أسباب وأعراض التهاب الدم عند الأطفال الصغار.
التهاب الدم عند كبار السن
بالإضافة إلى معرفة أسباب وأعراض التهاب الدم عند الأطفال الصغار لا بدّ من الحديث عن هذا المرض عندما يصيب كبار السن، إذ إنهم يكونون أكثر عرضةً لحدوث التهاب الدم بسبب الحالات المرضية الأخرى الموجودة، مثل السرطان والسكري وغيرها، كما يقضون وقتًا طويلًا في المستشفى، وخاصةً في وحدة العناية المركزة، كما يمكن أن تكون مناعتهم منخفضة بشكل كبير، وقد يكون إدراك العلامات المبكرة لالتهاب الدم أكثر صعوبةً من الأشخاص الأصغر سناً، ولكن مع تقدّم الأعراض قد تتطوّر وتتدهور حالة الشخص بسرعة، وغالبًا ما يكون سبب التهاب الدم عند كبار السن ناتجًا عن مشكلة في الجهاز التنفسي أو عدوى الجهاز البولي التناسلي، كما أنّ العلاج متوفر، ولكن قد يكون التهاب الدم الشديد قاتلًا في 50-60 % من الحالات بين كبار السن.[٦]
علاج التهاب الدم
يعتمد علاج هذه الحالة المرضية على معرفة أسباب وأعراض التهاب الدم لكل شخص، وهناك خيارات عديدة للعلاج يحدّد الطبيب أفضلها لكل شخص تبعًا لشدّة أعراضه وحالته الصحية، فقد يلجأ الأطباء إلى العلاج الداعم فقد يحتاج المريض إلى الأكسجين في حالة إصابة جهازه التنفسي، أو إلى استخدام جهاز غسيل الكلى في حالة كانت كليتيه متضررتان، وقد يحتاج المريض إلى إجراء عملية جراحية لإزالة القيح المتجمّع أو الغرغارينا أو الأنسجة المتضررة، ويشمل العلاج الدوائي لالتهاب الدم ما يأتي:[٣]
- المضادات الحيوية: يجب أن يتم البدء بها على الفور، حيث سيتلقى المريض أولًا المضادات الحيوية واسعة الطيف، والتي تكون فعّالة في محاربة مجموعة واسعة من الجراثيم، ويتم إعطاؤها للمريض عن طريق الوريد، ويتم إجراء اختبار زرع للبكتريا لتحديد المضاد الحيوي الفعّال بشكل خاص لمحاربتها.
- السوائل الوريدية: تستخدم السوائل الوريدية غالبًا عند الأشخاص المصابون بالتهاب الدم عادةً خلال ثلاث ساعات.
- قابضات الأوعية: والتي تستخدم وريديًا من أجل محاولة رفع ضغط الدم المنخفض، لأنّها تقوم بتضييق الأوعية الدموية للمريض.
الوقاية من التهاب الدم
بالإضافة إلى إدراك أسباب وأعراض التهاب الدم وطرق تشخيصها وعلاجها، لا بدّ من معرفة طرق الوقاية من هذه الحالة المرضية الخطيرة، إذ إنّ اتّخاذ خطوات لمنع انتشار العدوى يمكن أن يقلل من خطر الإصابة بالتهاب الدم وتشمل هذه الخطوات ما يأتي:[٢]
- متابعة جميع اللقاحات أو التطعيمات الخاصة بكل شخص.
- الحصول على مطعوم الإنفلونزا والالتهاب الرئوي، وأنواع الالتهابات الأخرى.
- الحفاظ على النظافة الشخصية في المنزل وفي المجتمع بشكل عام.
- اتّباع طرق وأساليب العناية المناسبة بالجروح وغسل اليدين والاستحمام بانتظام.
- الحصول على رعاية طبية فورية إذا توفّرت لدى الشخص أسباب وأعراض التهاب الدم مثل الحمّى وارتفاع الحرارة والقشعريرة والتعب والتقيّؤ والغثيان، إذ إنّه كل دقيقة تهمّ عندما يتعلق الأمر العلاج، أي أنّه كلما تلقى الشخص العلاج بشكل مبكّر، كلما كانت النتيجة أفضل.
التعافي من التهاب الدم
يتساءل الكثير من الأشخاص عن أسباب وأعراض التهاب الدم وطرق علاجه وعن إمكانية التعافي من هذا المرض الخطير، حيث يعتمد التعافي من التهاب الدم على شدّة الحالة المرضية وعلى أي شروط موجودة من قبل ظهور الأعراض، ويوجد الكثير من الناس الذين هم على قيد الحياة بعد إصابتهم بالتهاب الدم وقد تعافوا كليًا منه وقد تعرّفوا على أسباب وأعراض التهاب الدم الذين تعرّضوا إليه لمحاولة تجنّبه في المستقبل، ومع ذلك يوجد أشخاص آخرين لم يتعافوا تمامًا وأصيبوا بآثار دائمة، وتقول مؤسسة Sepsis Trust في المملكة المتحدة إنّ التعافي قد يستغرق إلى ما يصل إلى 18 شهرًا قبل أن يبدأ الناجون في الشعور بأنّ صحتهم جيدة كما كانت قبل المرض، كما ويقول تحالف Sepsis أنّ حوالي 50 % من اللذين تعافوا من التهاب الدم، ما زالوا يعانون من متلازمة ما بعد التهاب الدم، ويقول التحالف أيضًا أنّ أعراض هذه المتلازمة تتضمن تأثيرات طويلة المدى كالآتي:[٢]
- تلف الأعضاء.
- الأرق والكوابيس.
- تلف العضلات وآلام المفاصل.
- الإعياء والتعب العام.
- ضعف التركيز والإدراك.
- انخفاض الأداء والإدراك المعرفي.
- انخفاض احترام الذات.
- يمكن أن تؤدي الحالات الشديدة لالتهاب الدم إلى الموت.
الفرق بين التهاب الدم والتهاب الأوعية الدموية
تختلف أسباب وأعراض التهاب الدم عن أسباب وأعراض التهاب الأوعية الدموية، إذ يعدّ الثاني مرضًا مختلفًا عن التهاب الدم بشكل كلّي، فالتهاب الأوعية الدموية هو إصابة بعض أو جميع الأوعية الدموية في الجسم بعدوى التهابية، ويمكن أن تؤثّر هذه الحالة المرضية على أجزاء مختلفة من الجسم، ويعتمد التأثير والأعراض على الجزء المصاب، ويسمى التهاب الأوعية الدموية أيضًا التهاب الأوعية والتهاب الشرايين، ويؤدّي هذا الالتهاب إلى حدوث تغيّرات في جدران الأوعية الدموية، والتي قد تشمل الندوب والضعف والضيق والسماكة، وفي بعض الحالات، وقد تتأثر الأعضاء في الجسم، خاصةً إذا لم تتلق ما يكفي من الدم المغذّي والغني بالأكسجين، ممّا يؤدّي إلى تلف الأعضاء، وفي بعض الأحيان قد يؤدّي هذا المرض إلى الموت، وفي الواقع هناك نوعان من التهاب الأوعية الدموية، الأولي والثانوي الذي ينتج عن مرض آخر كالإصابة بعدوى ما وبأمراض الجهاز المناعي أو بالسرطان أو بعض التفاعلات التحسسّية، ويتم علاج التهاب الأوعية الدموية باستخدام العلاج الدوائي الآتي:[٧]
- الستيروئيدات القشرية: والتي تستخدم تحت إشراف الطبيب المختص لتخفيف الحالات الالتهابية، ولكنّها قد تؤدّي إلى آثار جانبية خطيرة مثل زيادة الوزن والإصابة بمرض السكري وهشاشة العظام.
- أدوية الجهاز المناعي: إذا لم يستجب الشخص جيدًا للعلاج بالستيروئيدات القشرية، فقد يصف الطبيب أدوية الجهاز المناعي والتي تمنع خلايا الجهاز المناعي التي تسبب الالتهابات، على سبيل المثال، آزوثيوبرين وسيكلوفوسفاميد.
كما وتختلف علامات وأعراض التهاب الأوعية الدموية اعتمادًا على نوع ومكان الأوعية الدموية التي تتأثّر وكذلك الأعضاء التالفة، إن وجدت، وفي الواقع تتضمّن الأعراض العامّة لهذا المرض ما يأتي:
- الحمّى الشديدة.
- الوهن والتعب العام.
- فقدان الوزن.
- فقدان الشهية.
- الشعور بآلام في المفاصل والعضلات.
- الشعور بالخدر والضعف في العضلات كافةً.
المراجع[+]
- ↑“Sepsis”, www.medlineplus.gov, Retrieved 1-10-2019. Edited.
- ^أبت“Sepsis”, www.healthline.com, Retrieved 1-10-2019. Edited.
- ^أب“Sepsis”, www.mayoclinic.org, Retrieved 02-10-2019. Edited.
- ↑“What is Sepsis?”, www.webmd.com, Retrieved 02-10-2019. Edited.
- ↑“Sepsis”, www.my.clevelandclinic.org, Retrieved 02-10-2019. Edited.
- ^أب“Sepsis: What you need to know”, www.medicalnewstoday.com, Retrieved 02-10-2019. Edited.
- ↑“What is vasculitis?”, www.medicalnewstoday.com, Retrieved 02-10-2019. Edited.